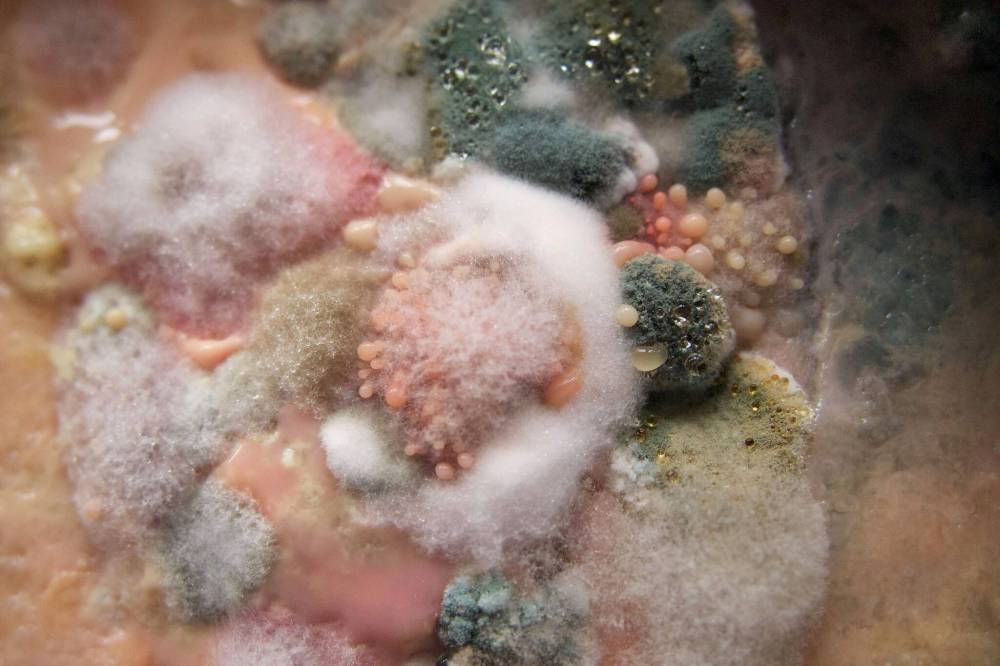
Susan Gibson photo
Alive — Prairie Fusion Arts & Entertainment, Portage la Prairie

Flash forward
Read this article for free:
or
Already have an account? Log in here »
To continue reading, please subscribe:
Monthly Digital Subscription
$0 for the first 4 weeks*
- Enjoy unlimited reading on winnipegfreepress.com
- Read the E-Edition, our digital replica newspaper
- Access News Break, our award-winning app
- Play interactive puzzles
*No charge for 4 weeks then price increases to the regular rate of $19.00 plus GST every four weeks. Offer available to new and qualified returning subscribers only. Cancel any time.
Monthly Digital Subscription
$4.75/week*
- Enjoy unlimited reading on winnipegfreepress.com
- Read the E-Edition, our digital replica newspaper
- Access News Break, our award-winning app
- Play interactive puzzles
*Billed as $19 plus GST every four weeks. Cancel any time.
To continue reading, please subscribe:
Add Free Press access to your Brandon Sun subscription for only an additional
$1 for the first 4 weeks*
*Your next subscription payment will increase by $1.00 and you will be charged $16.99 plus GST for four weeks. After four weeks, your payment will increase to $23.99 plus GST every four weeks.
Read unlimited articles for free today:
or
Already have an account? Log in here »
Hey there, time traveller!
This article was published 29/03/2025 (217 days ago), so information in it may no longer be current.
The FLASH Photographic Festival is marking its 10th anniversary in style.
The annual celebration of photography and lens-based art will extend across the province, with exhibits at 56 venues in Winnipeg, rural and northern Manitoba.
They include larger art galleries, such as WAG-Qaumajuq and the Art Gallery of Southwestern Manitoba, artist-run centres and non-traditional venues, such as libraries, restaurants, cafés and bars.
The event, which also features panel discussions, talks, workshops, film screenings and photo walks, runs the month of April.
For more information, go to: flashfest.net
Sam Baardman photo Sunset on the Mendenhall — Verde Juice Bar, Winnipeg
Susan Gibson photo
Alive — Prairie Fusion Arts & Entertainment, Portage la Prairie

Zac Ironstand photo
Osborne Ghost — Urban Shaman Contemporary Indigenous Art, Winnipeg

Sheila Spence photo
If William Morris was a Woman — Mennonite Heritage Centre Gallery, Winnipeg

Lisa Stinner photo
Tomorrowland (plants) — C’cap: Centre for Cultural and Artistic Practices, Winnipeg

Michelle Sound photo
Mother Tongue (1) — Art Gallery of Southwestern Manitoba, Brandon

Noelle Drimmie photo
Milk — NorVa, Flin Flon

Sarah Crawley photo
at the water’s edge — Martha Street Studio, Winnipeg

Ryszard Hunka photo
Happy Heart — Platform Centre Members’ Wall, Winnipeg
